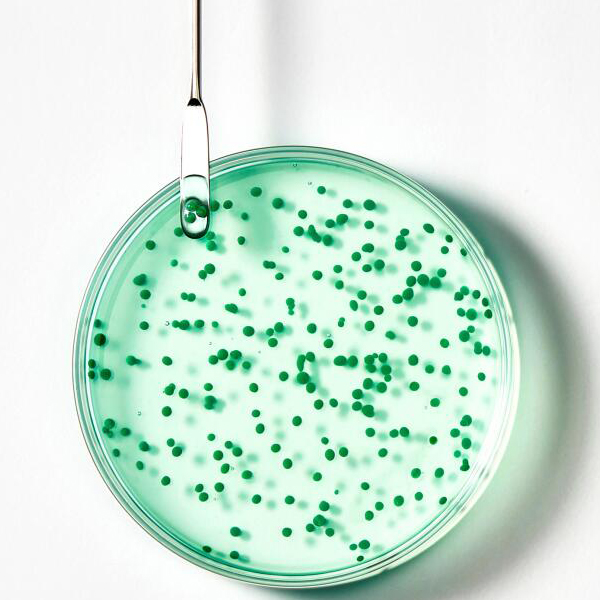
RENÉ FURTERER FORTICEA CHAMPÚ FORTIFICANTE REVITALIZANTE (200ml)

RENÉ FURTERER - FORTICEA CHAMPÚ FORTIFICANTE REVITALIZANTE (200ml)
- Ver todos los productos RENÉ FURTERER
- Ver todos los productos de CHAMPÚ de RENÉ FURTERER
FORTICEA Champú energizante
Aporta vigor al cabello - Fortalece las fibras capilares
Una textura icónica con micro-esferas de aceites esenciales. Como si se tratase de una invitación a un masaje, estallan delicadamente bajo las yemas de los dedos durante la aplicación, para liberar sus exquisitos poderes directamente sobre el cuero cabelludo en una espuma cremosa y ultrasensorial.
¿Cúales son sus beneficios?
• FORTIFICA y REVITALIZA: enriquecido con extracto de guaraná, un energizante natural, así como con vitaminas y aceites esenciales, ayuda al cabello a recuperar fuerza y vitalidad. El cabello, energizado, queda ligero y fácil de peinar.
• LIMPIA CON SUAVIDAD: formulado con un 97 % de ingredientes de origen natural y sin tensioactivos sulfatados, este champú purifica suavemente el cuero cabelludo y fortalece el cabello desde la raíz.
• FÓRMULA SENSORIAL: la textura en gel transparente y brillante, repleta de preciosas micro-esferas de aceites esenciales, envuelve el cabello con una fragancia fresca y tonificante, con notas de cítricos y tomillo.
TEXTURA
Una textura icónica con micro-esferas de aceites esenciales que estallan con suavidad al emulsionar la fórmula para liberar sus propiedades estimulantes.
Aroma del contenido Una fragancia fresca y vigorizante con notas chispeantes de cítricos y tomillo.
Modo de empleo
Uso frecuente
Paso 1
Aplicar sobre el cuero cabelludo húmedo.
Paso 2
Emulsionar y masajear con movimientos circulares desde la nuca hasta la parte superior de la cabeza.
Paso 3
Dejar actuar de 1 a 3 minutos. Aclarar abundantemente.
* Web del fabricante/laboratorio: RENÉ FURTERER

Iraltone Hair Boosters los bebibles para la caída del cabello 30-09-2025
Descubre las diferencias entre Iraltone Hair Resilience Booster y Iraltone Hair Efflu Booster, cómo elegir el más adecuado para ti y cómo integrarlo en tu rutina para fortalecer el cabello y recuperar densidad

Tratamiento Unisex para la caída del cabello: Iraltone AGA 5-Alfa Supreme 15-09-2025
Cómo frenar la caída del cabello con cápsulas, la pérdida de pelo afecta tanto a hombres como a mujeres y no es solo un problema estético

La rutina anticaída de Phyto 11-03-2022
Tengo la rutina anticaída de Phyto perfecta para frenar la caída y ayudar a fortalecer el cabello. ¿Sabías que la caída masculina y femenina son distintas?

Mitos y errores comunes sobre la caída capilar 15-10-2020
Déjate de mitos y ponte en manos de profesionales capilares como Phyto

Dime cómo es tu pelo y te diré qué champú necesitas 04-09-2019
Dime cómo es tu pelo y te diré qué champú necesitas

¿Sabes qué es el champú seco? 06-11-2018
El champú seco es una solución rápida para disfrutar de un pelo limpio en menos de 5 minutos.

Se me cae mucho el pelo, ¿qué hago? 15-10-2018
Un pelo, dos pelos, tres pelos... ¡Es normal que se te caiga el pelo, no te obsesiones!

CONSEJOS IMPRESCINDIBLES PARA UN CABELLO TEÑIDO 01-09-2017
Toda decoloración implica un proceso agresivo sobre el cabello, conoce los consejos imprescindibles para lucir un cabello SANO!

COSMETICA MASCULINA 100 % NATURAL 11-06-2017
Una nueva y eficaz propuesta en cosmética masculina con ingredientes 100 % naturales para el cuidado de piel, cuerpo y cabello.

¡Frena la caída del cabello! 19-11-2016
La pérdida o caída del cabello, así como su adelgazamiento (el pelo se vuelve muy fino) es uno de los problemas capilares más habituales, tanto para hombres como para mujeres.

Champús de queratina: ¡Repara tu cabello! 23-09-2016
Hace ya un tiempo que se empezó a hablar de los champús de queratina y, sin duda alguna, están más de moda que nunca. Por eso en Farmacia Soler os queremos explicar qué son y para qué sirven. ¿Necesitas un champú de queratina? ¡Sigue leyendo!

¡Qué no se te caiga el pelo! 29-06-2016
Sabemos que la pérdida de cabello es uno de los problemas estéticos más habituales, principalmente en hombres, pero también en las mujeres.

¡Cuidado! El pelo también se quema! 15-06-2016
Cuando preparamos la bolsa para la playa es importante que reparemos también en productos para el cabello, ya que el sol tiene tendencia a quemarlo, romperlo, volverlo poroso y apaga los colores y aclara los tonos naturales.

¡Aclara tu cabello sin tintes! 23-05-2016
Con el verano parece que apetece lucir el pelo más claro, con reflejos rubios o con mechas californianas que dan un look muy veraniego y actual.. Pero los tintes no son buenos aliados, y mucho menos si vamos a la playa, tomamos el sol o vamos a...

Anti-edad para el cabello! 08-04-2016
Os presentamos lo último de KLORANE para el cuidado del cabello: la Innovación Anti-edad al Extracto Esencial de Olivo.

¿Se te cae el pelo? 06-04-2016
Aunque las mujeres sufrimos menos caída del cabello producida por la herencia, hay motivos por los que podemos notar una caída excesiva del cabello, sobretodo en el cambio de estaciones. Una mala alimentación, productos químicos o abuso de...

Cuida tu cabello con JÀSÖN 11-03-2016
En 1959, mientras las grandes compañías probaban nuevos químicos para crear productos de cuidado personal, un grupo de pensadores independientes emprendieron un camino de regreso a ingredientes sencillos y saludables, probados como seguros y para...

A cada tipo de cabello, su champú 19-02-2016
¿Sabes qué champú es el ideal para tu pelo? Aquí van nuestras recomendaciones!

Rutina de cuidado del cabello 17-02-2016
Muchas veces hablamos de diferentes rutinas de cuidado de nuestra piel, ¿pero y el cabello? Este también requiere de una rutina de cuidado para mantenerlo sano, cuidado y brillante.

Y tú, ¿qué champú utilizas? 21-10-2015
Poco a poco todos hemos tomado conciencia de que cada tipo de piel es un mundo y, por tanto, necesita de productos específicos. ¿Y el cabello? ¿Por qué muchas de nosotras seguimos utilizando el mismo champú para toda la familia?

Cuida tu cabello este verano con la gama Solaire de René Furterer 31-07-2015
¿Quieres conocer los imprescindibles para cuidar tu cabello este verano? ¡Sigue leyendo!

¡Este verano no olvides proteger también tu pelo! 30-07-2015
Especial protección solar para cabello.

EL VERANO…ENEMIGO DE NUESTRO CABELLO? 18-06-2014
Ya tenemos aquí el ansiado verano, ya llega el buen tiempo, las vacaciones, y las horas de playa y de exposición al sol. Por ello e igual que cuidamos, protegemos e hidratamos nuestra piel, también debemos hacerlo con el cabello.

René Furterer cuida tu cabello con las plantas 31-03-2014
‘’Aprendí durante mi infancia en la Provenza varias recetas de mi abuela. Me enseñó a conocer las plantas y sus propiedades curativas’’ RENE FURTERER